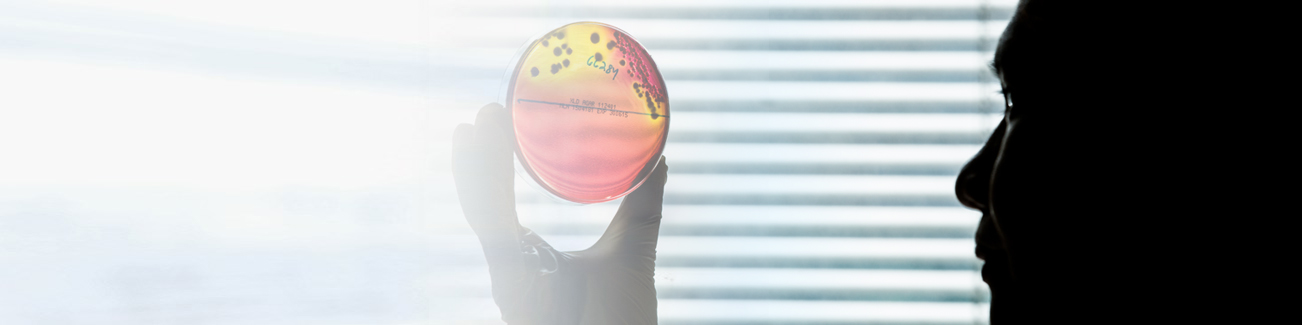
Developments

LAB HOURS: MON - THU and SAT : 9:00 AM to 9:00 PM
FRI and SUN : 9:00 AM to 6:00 PM
online services 

| New In House Cytogenetics Laboratory | Click to download |
| G6PDH and HLA B27 -- New In-House Test at FML | Click to download |
| Lysosomal Enzyme Diagnostics | Click to download |
| ImuPro testing in UAE exclusively performed at Freiburg Medical Laboratory, Dubai | Click to download |
| H. pylori Culture and Sensitivity - Changed List of Antibiotics | Click to download |
Offering a wide range of unique and state-of-the-art diagnostics services.

Specialties

Parameter Listing

Lab hours
MON - THU and SAT 9:00 AM to 9:00 PM | FRI and SUN : 9:00 AM to 6:00 PM